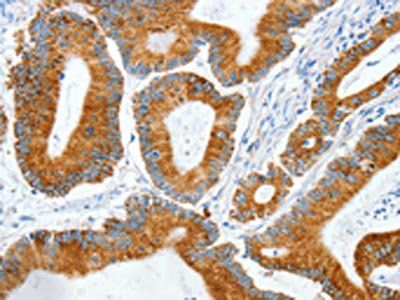
MANF Antibody

You have no items in your shopping cart.
MANF Antibody
Description
Research Area
Images & Validation
−| Tested Applications | ELISA, IF, IHC-P, WB |
|---|---|
| Reactivity | Human, Mouse, Rat |
| Predicted Reactivity | Bovine |
| Application Notes |
Key Properties
−| Antibody Type | Primary Antibody |
|---|---|
| Host | Rabbit |
| Clonality | Polyclonal |
| Isotype | IgG |
| Immunogen | MANF antibody was raised against a 12 amino acid synthetic peptide from near the carboxy terminus of human MANF.The immunogen is located within the last 50 amino acids of MANF. |
| Target | MANF |
| Molecular Weight | Predicted: 20kDObserved: 18 kD |
| Purification | MANF Antibody is Protein A purified. |
| Conjugation | Unconjugated |
Storage & Handling
−| Storage | Maintain refrigerated at 2-8°C for up to 2 weeks. For long term storage store at -20°C in small aliquots to prevent freeze-thaw cycles. |
|---|---|
| Form/Appearance | Liquid |
| Buffer/Preservatives | MANF Antibody is supplied in PBS containing 0.02% sodium azide. |
| Concentration | 1 mg/mL |
| Disclaimer | For research use only |
Alternative Names
−Similar Products
−ARP rabbit pAb Antibody [orb766914]
ELISA, IF, IHC, WB
Human, Mouse, Rat
Polyclonal
Unconjugated
100 μlMANF Antibody [orb1239620]
ELISA, IF, IHC-P, WB
Bovine
Human, Mouse, Rat
Rabbit
Polyclonal
Unconjugated
0.02 mg, 0.1 mgMANF/ARMET Antibody [orb1537855]
ELISA, IF, IHC, IHC-P, WB
Human, Mouse, Rat
Rabbit
Polyclonal
Unconjugated
0.05 mg

Quality Guarantee
Explore bioreagents carefree to elevate your research. All our products are rigorously tested for performance. If a product does not perform as described on its datasheet, our scientific support team will provide expert troubleshooting, a prompt replacement, or a refund. For full details, please see our Terms & Conditions and Buying Guide. Contact us at support@biorbyt.com.

KO Validation in HEK293T Cells. Loading: 10 µg of HEK293T WT cell lysates or MANF KO cell lysates. Antibodies: MANF orb1239622 (1 µg/mL) and beta-actin orb1240312 (1 µg/mL), 1 h incubation at RT in 5% NFDM/TBST. Secondary: Goat Anti-Rabbit IgG HRP conjugate at 1:10000 dilution.

Western Blot Validation in Human, Mouse (NIH/3T3) and Rat (YB2/0) Cell Lines. Loading: 15 µg of lysates per lane. Antibodies: MANF orb1239622, (2 µg /mL), 1h incubation at RT in 5% NFDM/TBST. Secondary: Goat anti-rabbit IgG HRP conjugate at 1:10000 dilution.

Western Blot Validation with Recombinant Protein. Loading: 30 ng of human MANF recombinant protein per lane. Antibodies: MANF orb1239622 (Lane 1: 0.125 µg /mL, Lane 2: 0.25µg /mL and Lane 3: 0.5 µg /mL), 1h incubation at RT in 5% NFDM/TBST. Secondary: Goat anti-rabbit IgG HRP conjugate at 1:10000 dilution. Observed at around 55kD.

Western Blot Validation in Human Tissues. Loading: 15 µg of lysates per lane. Antibodies: MANF orb1239622, (2 µg/mL), 1h incubation at RT in 5% NFDM/TBST. Secondary: Goat anti-rabbit IgG HRP conjugate at 1:10000 dilution.

Western Blot Validation in Mouse Tissues. Loading: 15 µg of lysates per lane. Antibodies: MANF orb1239622, (2 µg/mL), 1h incubation at RT in 5% NFDM/TBST. Secondary: Goat anti-rabbit IgG HRP conjugate at 1:10000 dilution.

Western Blot Validation in Rat Liver. Loading: 15 µg of lysates per lane. Antibodies: MANF orb1239622, 1h incubation at RT in 5% NFDM/TBST. Secondary: Goat anti-rabbit IgG HRP conjugate at 1:10000 dilution. Lane 1: 1 µg/mL, Lane 2: 2 µg/mL, Lane 3: 4 µg/mL.

Immunofluorescence Validation of MANF in Human Cervix. Immunofluorescent analysis of 4% paraformaldehyde-fixed human cervix cells labeling MANF with orb1239622 at 20 µg/mL, followed by goat anti-rabbit IgG secondary antibody at 1/500 dilution (green) and DAPI antibody (blue).

Immunofluorescence Validation of MANF in Human Colon. Immunofluorescent analysis of 4% paraformaldehyde-fixed human colon cells labeling MANF with orb1239622 at 5 µg/mL, followed by goat anti-rabbit IgG secondary antibody at 1/500 dilution (green) and DAPI antibody (blue).

Immunofluorescence Validation of MANF in Human Liver. Immunofluorescent analysis of 4% paraformaldehyde-fixed human liver cells labeling MANF with orb1239622 at 20 µg/mL, followed by goat anti-rabbit IgG secondary antibody at 1/500 dilution (green) and DAPI antibody (blue).

Immunofluorescence Validation of MANF in Mouse Pancreas. Immunofluorescent analysis of 4% paraformaldehyde-fixed mouse pancreas cells labeling MANF with orb1239622 at 20 µg/mL, followed by goat anti-rabbit IgG secondary antibody at 1/500 dilution (green) and DAPI antibody (blue).

Immunofluorescence Validation of MANF in Rat Liver. Immunofluorescent analysis of 4% paraformaldehyde-fixed rat liver cells labeling MANF with orb1239622 at 20 µg/mL, followed by goat anti-rabbit IgG secondary antibody at 1/500 dilution (green) and DAPI antibody (blue).

Immunohistochemistry Validation of MANF in Human Brain Tissue. Immunohistochemical analysis of paraffin-embedded human brain tissue using anti-MANF antibody (orb1239622) at 2.5 µg /ml. Tissue was fixed with formaldehyde and blocked with 10% serum for 1 h at RT; antigen retrieval was by heat mediation with a citrate buffer (pH6). Samples were incubated with primary antibody overnight at 4°C. A goat anti-rabbit IgG H&L (HRP) at 1/250 was used as secondary. Counter stained with Hematoxylin.

Localization and Immunocytochemistry Validation of MANF in adult zebrafish brain. (Chen et al., 2012). Co-immunostaining with anti-MANF antibodies (orb1239622) shows that majority of MANF-positive cells were HuC/D positive cells (fig. C-E) whereas a few MANF-positive cells were either glial (zrf-1) positive cells (fig. F-H) or TH1 positive cells (fig I-K). It indicates that MANF was mostly expressed in mature neuronal cells. MANF staining is shown in green.

KD Validation of MANF in Zebrafish Embryo (Chen et al., 2012). Western blot analysis with anti-MANF antibodies (orb1239622) was performed for MANF in 3dpf zebrafish embryo. After injected with a combination of two antisense splice-blocking morpholino oligonucleotides (MOsp), MANF expression was reduced by 85% as compared to the wild type.

Induced Expression Validation of MANF in Mouse C17.2 Neural Stem Cells (Almutawaa et al., 2014). Concentration- and time-dependent effects of Valproic acid (VPA) on MANF at 48 h examined by Western blot analysis with anti-MANF antibodies. MANF was markedly increased 48h after VPA treatment. Lanes 1–4: control, 0.5 mM VPA, 1 mM VPA, 3 mM VPA.
Documents Download
Request a Document
Protocol Information
MANF Antibody (orb1239622)
Participating in our Biorbyt product reviews program enables you to support fellow scientists by sharing your firsthand experience with our products.
Login to Submit a Review